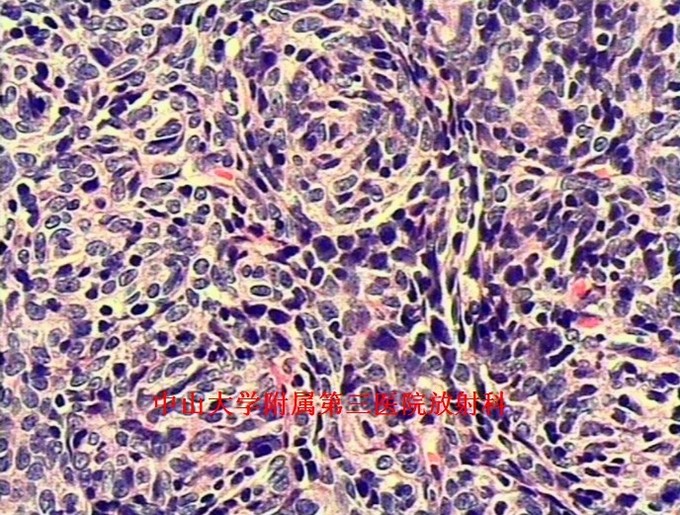

下载或打开 医联APP 查看完整评论
立即下载
打开APP
前纵膈占位:胸腺瘤一例
主诉 病史
主诉:咳嗽咳痰1月余,发现前纵隔肿物4天。 病史:老年女性,慢性病程。患者于1月余前出现反复咳嗽,咳痰,无痰中带血及咯血,遂至我院门诊就诊,行胸片及胸部CT检查提示“前纵隔肿物,胸腺瘤?”。
查体 辅查
查体:胸廓对称无畸形,无挤压痛,呼吸运动度及语颤对称,双肺叩诊清音,呼吸音清晰。 辅查:胸部CT示:前纵隔肿物,胸腺瘤?




诊断 处理
诊断:胸腺瘤。 治疗:排除手术禁忌症,于全麻下行“正中开胸胸腺扩大切除术”,病理提示:(胸腺肿物)符合胸腺瘤(AB型);免疫组化结果(②):CK(+),Vim(部分+),EMA(-),CK7(+),CK19(+),CK20(-),TdT(-),CD5(淋巴细胞+),CD1α(淋巴细胞+),Ki-67(淋巴细胞约60%+)。

随访 讨论
讨论:胸腺瘤是前纵隔最常见的肿瘤,约占成人前纵隔肿瘤的50%。目前,CT是公认的早期检出及诊断胸腺瘤的最佳方法。CT一般表现为:圆形、卵圆形或分叶状肿块,边界清晰,多数密度均匀,可见钙化;大部分肿瘤生长不对称,居于前纵隔的一侧;直径<2cm的胸腺瘤可仅表现为正常胸腺边缘局部隆起;增强扫描仅有轻度强化。主要应与胸腺增生鉴别,后者胸腺体积弥漫性增大,以左右两叶增厚为主要特征,但仍保持正常形态,而胸腺瘤为局部结节。 参考文献:杨蕊梦,许乙凯,冯婕等.胸腺瘤的MSCT-病理-临床综合诊断[J].放射学实践,2007,22(7):711-713.
发布于 15-09-30 18:10
